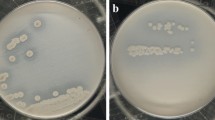

Abstract
Keratinophilic fungi is a rare group of fungi. They degrade keratin, which is a significant native material in hair, horns, nails, wool, hooves, feathers, and skin. These fungi are natural colonizers of keratinous substrate. They produce keratinase, which is a group of proteolytic enzyme that can catalyze the cleavage and cause hydrolysis of the highly stable and fibrous proteins: Keratins. Production of keratinase from a commercial perspective requires an integrated approach that combines optional fermentation condition, operational optimization, and effective downstream processing. The purpose of the present study was to select the keratinolytic fungal species isolated from the soil samples of Bhopal by hair baiting techniques. Total eleven fungal isolates show keratinophilic activity. Molecular identification of these isolates was confirmed by the sequence of ITSI, S8S, ITS region of their DNA sequences. The medium components and culture conditions have been optimized for the purpose of enhancing keratinase production through the comparison of shake versus static culture conditions, different pH, and temperatures in addition to different incubation time periods. The maximum amount of keratinase production was observed in the shake culture method, at 8 pH, 50 °C, and post 15 days of incubation. Of the reported isolates, eleven were observed to be good producers of keratinase. These fungal isolates can prove to be useful in environment-friendly cleanup of keratinic wastes. They might also be utilized for production of keratinase in large scales for industrial purposes.
Access provided by Autonomous University of Puebla. Download chapter PDF
Similar content being viewed by others
Keywords
4.1 Introduction
Soil encourages a large number of microorganisms and is one of the highest complicated microbial habitats that permit bacteria, fungi, and other micro-organisms to nurse their entire life. Soil is the shelter for several fungi, which are not noticed and explored in the environment (Pahare et al., 2018).
Keratinophilic fungi are a little, all around characterized and essential gathering of growths that colonize diverse keratinous substrates, and generate them to fragments of low atomic weight. These fungi are available on the earth with variable dispersion designs, which rely upon components, for example, human or animals (Kumar et al., 2013).
Keratinophilic means keratin-loving micro-organism. Keratinophilic fungi are natural colonizers of keratinous substrates. Few of them are keratinolytic and play a massive ecological character in the decay of insoluble fibrous proteins, keratins (Kushwaha & Guarro, 2000). Keratin has a place with the exceptionally heterogeneous group of fibrillar proteins of conservative structure. Countless extensions of disulfide bridges in keratins structure altogether impact its properties, specifically, high mechanical and substance obstruction. Keratin is highly stable and water insoluble. Common proteases like pepsin and papain are not capable of degrading keratin (Staroń et al., 2011).
Keratinase is a specific class of extracellular proteolytic inducible chemical with the ability of debasing insoluble keratin substrates. It is vital for hydrolyzing hair, plume, and collagen in the sewage framework amid wastewater treatment.
Human hair and nails are always in interaction with pollutants in the environment and waste exposed to fungal and bacterial contamination (Alghamdi et al., 2018). Recent studies have become an important clinical condition, which require attention to public health, because some of them are seriously harmful to human health. Health authorities must build up their health information campaigns, which cover not only serious disease prevention and treatment but also environmental hygiene.
4.1.1 Keratinases: Applications
Keratinolytic micro-organisms and keratinases may be utilized for multiple applications in a myriad of industries, like the detergent industry, leather production, food and feed industries, medical and pharmaceutical industries, waste management industries, etc. Compared to traditional microbial proteases, production of keratinases can be achieved at lower costs as the organisms are able to utilize the abundant keratinous waste as nitrogen and carbon source. Since elevated production cost is one of the main issues in the industrial production of enzymes, this methodology of utilization of abundant quantities of keratinous waste will make the process comparatively more economical while also increasing its application portfolio.
4.1.1.1 Detergent Industry
Proteases are widely utilized in the detergent industry as a safe alternative replacing harmful chemicals such as caustic soda. In addition to being used in washing detergents, keratinases may also be used as an additive in lens cleaning solutions, drain cleaning solutions, etc. (Nasaimento & Martin, 2006).
4.1.1.2 Leather Industry
The leather industry involves several steps of leather treatment with chemicals, such as sodium sulfide, sodium hydroxide, and lime. These chemicals are potent water pollutants along with solid wastes emerging due to these treatments (Sivakumar et al., 2012). Processing of leather with enzymes such as proteolytic, lipolytic, and glycolytic enzymes has emerged as a safe alternative (Bihari et al., 2010).
4.1.1.3 Food and Feed Industry
The National Research Development Corporation (NRDC), India, has recently utilized bifunctional chimeric keratinase from Bacillus sp. for the purpose of debittering amino acids in the processing of soy sauce. It was observed that this increased the taste of tea, and feather meal preparation along with other applications (www.nrdcindia.com). Usually, enzymes are useful in feed industries because of their part in the breakdown of the antinutritional elements in feed ingredients. In addition to that, this keratinase treatment improves the bioavailability of biomolecules in animal feed. It does so by assisting endogenous proteolytic enzymes of feeding animals to unwind the rigid structure of feed. However, often, this is restricted due to the high production costs, and therefore, low-cost keratinases can prove to be a useful alternative as a feed additive. Recently, many commercial enzymes, such as Versazyme, and Valkerase, etc., have been used as applications in animal feed preparations.
4.1.1.4 Fertilizer for Organic Farming
Composting of keratinous wastes using keratinolytic micro-organisms leads to gradual release of nitrogen fertilizers. This makes it a viable application in organic farming . This methodology has become one of the safest and most cost-effective technologies to resolve keratinous waste materials.
4.1.1.5 Biofuel Production
Poultry waste can be used as a viable source of biofuel. Keratinolytic micro-organisms and their keratinases can be employed in the utilization of these wastes for generation of natural gas (Puhl et al., 2009), methane gas fuel pellets (Gushterova et al., 2005), and biohydrogen (Saha et al., 2013).
4.1.1.6 Cosmetic and Pharmaceutical Applications
Non-collagenolytic keratinases have emerged as promising biocatalysts in the pharmaceutical as well as cosmetic industries. They have been illustrated as a useful ingredient in depilatory compositions for hair shaving formulations and skin lightening agents (Yang, 2012). Certain crude keratinases have also been demonstrated to elevate hair characteristics like weight, flexibility, brightness, softness, and strength; this illustrates that these can be applied in the creation of hair care products (Cao et al., 2012). Additionally, keratinases have shown the ability to degrade thickened layers of dead skin (hyperkeratosis) found around the toes and fingers, thereby promising to be an alternative to the conventional salicylic acid used for the treatment of such predilections (Gupta & Ramnani, 2006). In the same fashion, keratinases can be capable of peeling skin to remove acne, which is caused by the blockage of the sebaceous gland by keratins (Selvam &Vishnupriya, 2012).
4.2 Materials and Methods
4.2.1 Collection of Soil Samples
Soil samples of keratin containing waste were collected in polythene bags from the different sampling sites, brought to the laboratory, and analyzed.
4.2.2 Isolation of Keratinophilic Fungi
For the isolation of fungi, hair baiting technique was used (Vanbreuseghem, 1952).
4.2.3 Morphological Microscopic and Molecular Identification of Keratinophilic Fungi
Firstly, the fungi were indentified on the basis of morphological characteristics of the colony and microscopic examination. Molecular identification of isolated microorganisms was confirmed by the sequence of ITSI, 508 s, and ITS2 region of their DNA sequences.
4.2.4 Optimization of Culture Condition for Mass Production of Keratinase Enzyme
To optimize the culture conditions for mass production of keratinase enzyme by isolated soil microorganisms, a basal medium containing insoluble keratin was prepared with various pH (6, 7, 8, and 9) incubated on different temperatures (40, 45, 50, 55, and 60 °C) for various incubation periods (12, 15, 18, and 21 days) (Table 4.1).
4.2.5 Enzyme Production
The keratinase enzyme production was carried out in the basal medium by using a shaking flask. To begin the process, 5 mg of azokeratin was added in the basal medium: 2.5 ml of the all isolated fungal inoculums was added in 50 ml of medium and cultured on a rotary shaking incubator at 150 rpm and 37 °C for 72 h. After incubation, fermented broth was centrifuged at 5000 rpm for 20 min at 4 °C. The cell-free supernatant was collected and used for the assay of keratinase activity (Sivakumar et al., 2012).
4.2.6 Keratinase Assay
Keratinase activity was determined by taking 20 ml of 0.1 M Tris buffer (pH 8) containing 0.1% keratin and 40 μl of enzyme solution and was incubated for 30 minutes at 55 °C. The reaction was stopped with 500 μl of 0.1 mol-1 trichloroacetic acid (TCA) in 0.1 mol-1 Tris buffer, pH 8. The amount of protein present was assayed by the Lowry method using bovine serum albumin (BSA) as standard. The color developed was read at 660 nm (Jin et al., 2017).
4.3 Results
4.3.1 Morphological Characterization
Morphological characterization was performed and further confirmed by the National Center for Fungal Taxonomy (NCFT), New Delhi. All positive keratinophilic fungi were identified by colony morphology and lactophenol cotton blue microscopic staining method (Table 4.2).
4.3.2 Molecular Identification of Fungi
The genomic DNA was isolated from selected keratinophilic fungi using the CTAB method. The DNA was visualized on agarose gel and quantified for an accurate amount of DNA isolated. We have observed an average of 2.86 mg/μl genomic DNA from all major keratinophilic fungi.
The gene-specific primers were designed using coding sequence available at National Centre for Biological Information (NCBI). The primers were designed based on in silico PCR validations. Primers are supplied in lyophilized form and dissolved in recommended volume of sterile water or TE buffer result in 100 μM concentration.
The 100 μM concentration primers are used for master stock and aliquoted into 10 μM for PCR reactions. The targeted genes were amplified using thermal cycler and PCR reaction mixture. Different primers are required for identification of different set of genes in PCR Programme.
The primer may also vary in its melting temperature, and hence Tm values were pre-calculated and PCR program was designed based on Tm value for efficient annealing. The Tag Polymerase, a thermostable DNA polymerase, had a chain elongation capacity, 500 bases per second, and hence PCR program was designed based on gene length. Here, we have run several individual reactions and PCR trials for gene amplification and amplified gene was visualized on agarose gel with a standard DNA ladder. The primer used in the study was 550 bp in length.
The amplification products were sequenced for species identification. The DNA sequences of isolated strains were recited using basic local alignment search tool (BLAST) for species identification. The BLAST search showed that the sequence data of the isolated strain S1 shared 99% similarity with Fusarium solani and S2 shared 99% similarity with Curvularia lunata. The three isolated strains, identified as Gibberella pulicaris, Chrysoporium keratinophilum and Penicillium chrysogenum were S10, S3 and S9. DNA sequences of S5 and S 11 showed 90% matching with Aspergillus niger and A. flavus. Similarly, S7 and TS8 fungi found close similarity with Absidia species. Amplification of each primer pair was tested on a panel of strains representing Acremonium kiliense and A. restrictum, along with the genomic DNA of the isolate from which the library was generated.
All isolated strains were submitted in the Gen-Bank databases for the purpose of phylogenetic study. The gene bank accession numbers for fungi from S1 to S11 are shown in (Fig. 4.1).
4.3.3 Phylogenetic Analysis
In the phylogenetic tree (Fig. 4.1), all major keratinophilics were reported to be of a distant origin and do not have any close resemblance. The phylogenetic tree was constructed by the neighbor-joining method and Jaccard coefficient. There are three ancestors of isolates found in this study. Group one has two species, that is, Penicillum chrysogenum and Gibberella pulicaris. Aspergillus niger and Acremonium are in another group, whereas the third has two subgroups, one including Aspergillus flavus, Absidia californica, and Absida repens. The other subgroup includes Chrysosporium keratinophilum, Fusarium solani, Acremonium restrictum, and Curvularialuntana (Fig. 4.1).
4.3.4 Optimization of Culture Media for Keratinase Enzyme Production
4.3.4.1 Effect of Fermentation on Keratinase Enzyme
Maximum keratinase production was recorded in the shake culture method compared to static culture. Table 4.3 and Fig. 4.2 show the results of keratinase production by both techniques. Curvularialunata produced a maximum 43.5 U/ml keratinase while minimum 17.5 U/ml was observed in the culture medium containing Aspergillus flavus during the shake culture method. The highest amount (38.6 U/ml) of keratinase was produced by Fusarium solani and minimum 14.6 U/ml produced by Gibberellapulicaris during static culture technique. Data represent the mean and ± standard deviation for different methods. Although Table 4.3 and Fig. 4.2 show varied keratinase production in the two different methods, this difference, however, is not statistically significant (p is 0.32 at t-test static value) and t-test is calculated using “Microsoft Excel Version 2019.”
4.3.4.2 Effect of Temperature on Keratinase Enzyme Production
Different temperatures, such as 40 °C, 45 °C, 50 °C, 55 °C, and 60 °C, were tested to obtain the optimum temperature for the maximum production of keratinase by all isolates. Out of the temperatures tested as above, the maximum production of keratinase was observed to be at 50 °C (Table 4.4 and Fig. 4.3). Maximum keratinase (43.5 U/ml) at optimum temperature 50 °C was produced by Penicillium chrysogenum, while minimum keratinase (5.9 U/ml) was recorded at 40 °C temperature produced by Aspergillus flavus. Proteolytic activities of most organisms are seen to be at 30–37 °C, whereas some keratinolytic microbes show keratin-degrading capacities at higher temperatures. A nonparametric Kruskal-Wallis test applied on the data (the data fulfill the requirements for the test) shows that there was a statistically significant difference in the keratinase activity under different temperatures studied (p < 0.0001 for the test static H = 31.08).
4.3.4.3 Effect of pH on Keratinase Enzyme Activity
The medium adjusted on different pH values, (such as pH 6, 7, 8, and 9) was assayed to obtain the optimum pH for the maximum production of keratinase by all isolated keratinophilic microbes. From Table 4.5, it is clear that Penicillium chrysogenum is found to be the maximum enzyme-producing microorganism, which produced 4.01 U/ml keratinase at 8pH at 50 °C optimum temperature. pH 6 reduced the proteolytic activity of all isolates. The lowest enzyme (0.62 U/ml) production was found at pH 6 by Fusarium solani. There was a statistically significant difference in the keratinase activity under different pH values studied (p = 0.00001 for the test static H = 29.25) (Fig. 4.4) (Bewick et al., 2004).
4.3.4.4 Effect of Incubation Time
The effect of incubation period on keratinase production from keratinophilic fungi was studied for the incubation period from 12 days to 21 days as shown in Table 4.6 and Fig. 4.5. It was observed that the maximum enzyme production was attained between 15–18 days of incubation period. Incubation beyond the optimum time showed a rapid decline in the enzyme yield, as compared to the maximum (39.8 U/ml) at 15 hrs. Fusarium solani produced maximum (39.8 U/ml) keratinase enzyme at the incubation of 15 days and minimum (7.9 U/ml) was produced by Aspergillus flavus after 12 days of incubation. The Kruskal-Wallis test showed that there was a statistically significant difference between the overall keratinase production by the fungi under the different incubation periods studied (p = 0.004 at H statistic 13.15).
4.4 Discussion
The molecular identification was carried out by DNA bar-coding using the ITS region sequencing. The DNA sequences were compared to those in the databases using NCBI-BLAST. Eleven species were identified using DNA bar-coding with an identical range between 97–99%. It is also proposed that DNA region sequence is one of the most important tools for the identification of the fungal species isolated from environmental sources. Hence, it has been widely used to detect the soil fungal community, and as an improvement of the classical identifications (Alsohaili & Bani-Hasan, 2018).
Pakshir et al. (2013) used the molecular technique for the first time in Iran to identify keratinophilic fungi. In the current investigation, 11 species of eight genera were identified by molecular marker–based sequence analysis (Fig. 4.1).
In the present examination, Absidia californica and Absidia repens were also found majorly in the soil sample of dumping sites. These fungi also have a great keratin-solubilizing potential. The current findings are in agreement with previous reports about Absidiaas keratinophilic fungi. Morphological criteria and molecular marker for clear distinction of Absidia was used. Different species of clinically significant zygomycetes including 2 species of Rhizopus, 3 species of Mucor, 2 species of Cunninghamella, as well as 1 strain each of Rhizomucorpusillus and Absidiacorymbifera were identified by molecular techniques (Iwen et al., 2011).
Majority of reports on Keratinase production are under submerged shaking/ static conditions (Cai et al., 2011). It is difficult to compare the production condition for Keratinase due to a variety of organisms and the methods of cultivation.
In comparison to the present findings, other studies reported that maximum enzyme activity was obtained within 96 h (150 U/ml and 90 U/ml for Chrysosporiumand Microsporumrespectively) of cultivation at pH 7.0, 30 °C. The optimal conditions for the keratinolytic activity of both enzymes were found to be at pH 9.0 and temperature 50 °C; however, the enzymes showed stability over a broad range of pH between 7.0 and 10.0 and temperature 30 °C–50 °C (Kanchana, 2013).
Similar studies were conducted by different scientists. Three factors, temperature, pH, and manitol, were used for keratinase optimization (Shankar et al. 2014). Similar work for keratinase production employing response surface methodology was performed (Ramnani & Gupta, 2004; Hashemet al., 2018). Impact of different substrates, temperature, pH and protease inhibitors, lessening operators, and metal particle supplements in the generation medium on enzyme creation was studied (Yadav et al., 2011).
Previous reports show that the activity of keratinolytic enzyme produced by Aspergillus flavus effectively degraded feather substrate (Mini et al., 2015). Extremely high and low pH values showed complete loss of activity for most enzymes. Alkaline pH possibly supported keratin degradation as higher pH modified cysteine residues, making it accessible for enzyme action. Keratin degradation took incubation time for enzyme production from 24 h to several days. This is probably involved in the complex procedure of keratinolysis of these microbes (Kumawat et al., 2013). The harvesting time of 72 h was found to be ideal for maximum enzyme production.
These results showed similarity with our findings that keratinase enzyme production was maximum at 8 pH, between 15 and 18 days of incubation at 50 °C. Although the mean enzyme activity is maximum at 18 days of incubation period (Table 4.6), fungi such as Fusarium solani and Penicillium chrysogenum did show better activity after 15 days of incubation. Also, some fungi showed good activity after 21 days of incubation. For more precise optimization, enzyme activity could be observed on consecutive days between 15 to 21 days of incubation.
4.5 Conclusion
The findings concluded that total eleven keratinophilic fungi were isolated from the soil of Bhopal. All these fungi showed good keratinase production in shake culture method at 8 pH, 50 °C temperature, between 15–18 days of incubation period. These fungal isolates will be useful in eco-friendly and environment cleanup process of keratinic wastes. They may also be used for large-scale production of keratinase for industrial purposes. This research is suggestive of potential optimization scheme and its scope alongside the development of optimal medium compositions and culture conditions, for the production of keratinolytic enzyme that can be useful for developing entrepreneurship.
References
Alghamdi, S., Alotaibi, A., Haya, A., Al-SubaiMunira, Z., & Alwakeel Suaad, S. (2018). Isolation and identification of microbial and fungal flora from female hair samples in Riyadh Saudi Arabia. International Journal of Environment, Agriculture and Biotechnology, 3(11–5), 2456–1878.
Alsohaili, S. A., & Bani-Hasan, B. M. (2018). Morphological and molecular identification of fungi isolated from different environmental sources in the Northern Eastern Desert of Jordan. Jordan Journal of Biological Sciences, 11(3), 329–337.
Bewick, V., & Chakl, & Bali, J. (2004). Statistics review 10: Further non parametric methods. Critical Care, 8, 196–199.
Bihari, Z., Videki, D., Mihalik, E., et al. (2010). Degradation of native feathers by a novel keratinase-producing, thermophilic isolate, Brevibacillus thermoruber T1E. Zeitschrift für Naturforschung. Section C, 65, 134–140.
Cai, S. B., Huang, Z. H., Zhang, X. Q., Cao, Z. J., Zhou, M. H., et al. (2011). Identification of a keratinase-producing bacterial strain and enzymatic study for its improvement on shrink resistance and tensile strength of wool- and polyester-blended fabric. Applied Biochemistry and Biotechnology, 163(1), 112–126.
Cao, Z. J., Lu, D., Luo, L. S., Deng, Y. X., Bian, Y. G., et al. (2012). Composition analysis and application of degradation products of whole feathers through a large scale of fermentation. Environmental Science and Pollution Research, 19(7), 2690–2696.
Gupta, R., & Ramnani, P. (2006). Microbial keratinases and their prospective applications: An overview. Applied Microbiology and Biotechnology, 70, 21–33.
Gushterova, A., Vasileva-Tonkova, E., Dimova, E., et al. (2005). Keratinase production by newly isolated Antarctic actinomycete strains. World Journal of Microbiology and Biotechnology, 21, 831–834.
Hashem, A. M., Abdel-Fattah, A. M., Ismail, S. A., El-Gamal, M. S., Esawy, M. A., & Emran, M. A. (2018). Optimization, characterization and thermodynamic studies on B. 137 licheniformis ALW1 keratinase. Egyptian Journal of Chemistry, 61(4), 591–607.
Iwen, P. C., Thapa, I., & Bastola, D. (2011). Review of methods for the identification of zygomycetes with an emphasis on advances in molecular diagnostics. Laboratory Medicine, 42(5), 260–266.
Jin, H. S., Park, S. Y., Kin, K., Leu, Y.-J., Nam, G.-W., Kang, N. J., et al. (2017). Development of a Keratinase activity assay using recombinant chicken feather keratin substrates. PLoS One, 12(2), e0172712.
Kanchana, R. (2013). Utilization of biodegradable keratin containing wastes by enzymatic treatment. International Journal of Pharmacological and Biological Sciences, 4(1B), 117–126.
Kumar, R., Mishra, R., Maurya, S., & Sahu, H. B. (2013). Isolation and identification of keratinophilic fungi from garbage waste soils of Jharkhand region of India. European Journal of Experimental Biology, 3(3), 600–604.
Kumawat, T. K., Sharma, V., Seth, R., & Sharma, A. (2013). Diversity of keratin degrading fungal flora in industrial area of Jaipur and keratinolytic potential of Trichophyton mentagrophytes and Microsporumcanis. International Journal of Biotechnology and Bioengineering Research, 4(4), 359–364.
Kushwaha, R. K. S., & Guarro, J. (Eds.). (2000). Biology of dermatophytes and other keratinophilic fungi. RevistaIbero americana de Micología.
Mini, K. D., George, S. M., & Mathew, J. (2015). Screening and selection of fungus for keratinase production by solid state fermentation and optimization of conditions of SSF and formulation of low-cost medium for the production of keratinase by Aspergillus flavus S125. International Journal of Current Microbiology and Applied Sciences, 4(9), 535–548.
MS Excel (dentopreed by Microsoft).
Nasaimento, W. C. A., & Martin, M. L. L. (2006). Studies on the stability of Protease from Bacillus sp. & its Compatibility with commercial detergent. Bazilian Journal of Microbiology, 37, 307–311.
Pahare, S., Shukla, K., & Shukla, R. V. (2018). Keratinophilic fungi from warm, moist, cattle – house of Bilaspur Central – India. Journal of Microbiology & Experimentation, 6(2), 46–48.
Pakshir, K., Ghiasi, M. R., Zomorodian, K., & Gharavi, A. R. (2013). Isolation and molecular identification of keratinophilic fungi from public parks soil in Shiraz, Iran. BioMed Research International, 619576.
Puhl, A. A., Selinger, L. B., McAllister, T. A., et al. (2009). Actinomadurakeratinilytica sp. nov., a keratin degrading actinobacterium isolated from bovine manure compost. International Journal of Systematic and Evolutionary Microbiology, 59, 828–834.
Ramnani, P., & Gupta, R. (2004). Optimization of medium composition for keratinase production on feather by Bacillus licheniformis RG1 using statistical methods involving response surface methodology. Biotechnology and Applied Biochemistry, 40(20), 191–196.
Saha, S., Dhanasekaran, D., Shanmugapriya, S., et al. (2013). Nocardiopsis sp. SD5: A potent feather degrading rare actinobacterium isolated from feather waste in Tamil Nadu, India. Journal of Basic Microbiology, 53, 608–616.
Selvam, K., & Vishnupriya, B. (2012). Biochemical and molecular characterization of microbial keratinase and its remarkable applications. International Journal of Pharmaceutical and Biological Archive, 3(2), 267–275.
Shankar, T., Thangamathi, P., Sathiya, C., & Sivakumar, T. (2014). Statistical optimization of keratinase production by Bacillus thuringiensis. Journal of Global Biosciences, 3(2), 477–483.
Sivakumar, T., Shankar, T., Vijayabaskar, P., & Ramasubramanian, V. (2012). Optimization for keratinase enzyme production using bacillus thuringiensis TS2. Academic Journal of Plant Sciences, 5(3), 102–109.
Staroń, P., Banach, M., & Kowalski, Z. (2011). Keratin – Origins, properties, application. Chem, 65(10), 1019–1026.
Vanbreuseghem, R. (1952). Technique biologique pour I’ isolement des dermatophytes dusol. Annales de la Société Belge de MédecineTropicale, 32, 173–178.
Yadav, A. K., Vardhan, S., Yandigeri, M. S., Srivastava, A. K., & Arora, D. K. (2011). Optimization of keratin degrading enzyme from thermophilic strain of Streptomyces sclerotialus. Research Journal of Microbiology, 6, 693–705.
Yang, Y. (2012). Skin-whitening and freckle-dispelling essence and preparation method thereof. Patent: CN102614104.
Author information
Authors and Affiliations
Editor information
Editors and Affiliations
Rights and permissions
Copyright information
© 2022 The Author(s), under exclusive license to Springer Nature Switzerland AG
About this chapter
Cite this chapter
Mishra, R., Tamrakar, S. (2022). Production, Partial Optimization, and Characterization of Keratinase Enzyme by Fungal Species Isolated from Soil of Bhopal. In: Shukla, A.C. (eds) Applied Mycology. Fungal Biology. Springer, Cham. https://doi.org/10.1007/978-3-030-90649-8_4
Download citation
DOI: https://doi.org/10.1007/978-3-030-90649-8_4
Published:
Publisher Name: Springer, Cham
Print ISBN: 978-3-030-90648-1
Online ISBN: 978-3-030-90649-8
eBook Packages: Biomedical and Life SciencesBiomedical and Life Sciences (R0)